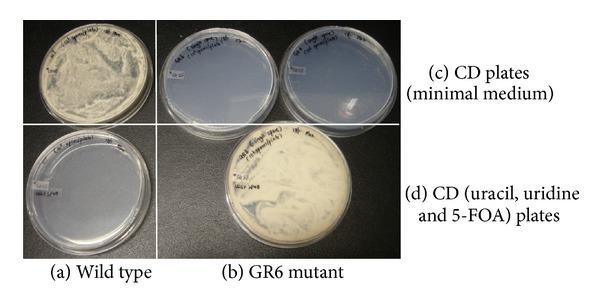
https://cdn.ncbi.nlm.nih.gov/pmc/blobs/c7d5/3864154/5ee51994eb2e/TSWJ2013-634317.003.jpg

米曲霉S1菌株pyrG突变体作为异源蛋白生产宿主的开发。
Development of a pyrG mutant of Aspergillus oryzae strain S1 as a host for the production of heterologous proteins.
作者信息
Ling Selina Oh Siew, Storms Reginald, Zheng Yun, Rodzi Mohd Rohaizad Mohd, Mahadi Nor Muhammad, Illias Rosli Md, Abdul Murad Abdul Munir, Abu Bakar Farah Diba
机构信息
School of Biosciences and Biotechnology, Faculty of Science and Technology, Universiti Kebangsaan Malaysia, 43600 Bangi, Selangor, Malaysia.
Centre for Structural and Functional Genomics, Concordia University, 7141 Sherbrooke Street West, Montréal, Québec, Canada H4B 1R6 ; Department of Biology, Concordia University, 7141 Sherbrooke Street West, Montréal, Québec, Canada H4B 1R6.
出版信息
ScientificWorldJournal. 2013 Nov 30;2013:634317. doi: 10.1155/2013/634317. eCollection 2013.
The ease with which auxotrophic strains and genes that complement them can be manipulated, as well as the stability of auxotrophic selection systems, are amongst the advantages of using auxotrophic markers to produce heterologous proteins. Most auxotrophic markers in Aspergillus oryzae originate from chemical or physical mutagenesis that may yield undesirable mutations along with the mutation of interest. An auxotrophic A. oryzae strain S1 was generated by deleting the orotidine-5'-monophosphate decarboxylase gene (pyrG) by targeted gene replacement. The uridine requirement of the resulting strain GR6 pyrGΔ0 was complemented by plasmids carrying a pyrG gene from either Aspergillus nidulans or A. oryzae. β -Galactosidase expression by strain GR6 pyrGΔ0 transformed with an A. niger plasmid encoding a heterologous β -galactosidase was at least 150 times more than that obtained with the untransformed strain. Targeted gene replacement is thus an efficient way of developing auxotrophic mutants in A. oryzae and the auxotrophic strain GR6 pyrGΔ0 facilitated the production of a heterologous protein in this fungus.
利用营养缺陷型标记生产异源蛋白的优势包括能够轻松操控营养缺陷型菌株及其互补基因,以及营养缺陷型选择系统的稳定性。米曲霉中的大多数营养缺陷型标记源自化学或物理诱变,这种诱变可能在产生目标突变的同时,带来不良突变。通过靶向基因置换缺失乳清苷-5'-单磷酸脱羧酶基因(pyrG),构建了营养缺陷型米曲霉菌株S1。携带构巢曲霉或米曲霉pyrG基因的质粒可补充所得菌株GR6 pyrGΔ0对尿苷的需求。用编码异源β-半乳糖苷酶的黑曲霉菌粒转化GR6 pyrGΔ0菌株,其β-半乳糖苷酶表达量比未转化菌株至少高150倍。因此,靶向基因置换是在米曲霉中构建营养缺陷型突变体的有效方法,营养缺陷型菌株GR6 pyrGΔ0有助于在该真菌中生产异源蛋白。